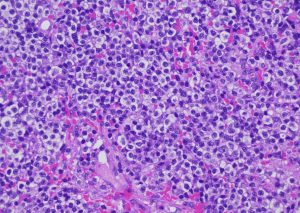

(その他の症例:22)脂漏症の分類はたまに悩みます

脂漏症は原発なのか?続発なのか?から考えます。続発だと犬アトピー性皮膚炎からが多いのですが、そうすると症例としてはアトピーに分類すべきか迷いますね・・・オマケに脂漏症から続発してマラセチア皮膚炎も起こりますし、そうしたら感染症に分類・・・大事なのは1つの病名だけで分類できないと言う事です!治療も当然一つにはなりません。

脂漏症は原発なのか?続発なのか?から考えます。続発だと犬アトピー性皮膚炎からが多いのですが、そうすると症例としてはアトピーに分類すべきか迷いますね・・・オマケに脂漏症から続発してマラセチア皮膚炎も起こりますし、そうしたら感染症に分類・・・大事なのは1つの病名だけで分類できないと言う事です!治療も当然一つにはなりません。
上皮向性リンパ腫は一般の獣医師だと生涯で1回診るかどうか?位だと思います。もし出会っていても生検までして確定診断に至っていない事も多いでしょう。当院では皮膚科認定医として広く来院頂いているので割と診断と治療をします。先日も新しい子で診断したのですが、悲惨な話が多いですが必ずしも予後不良とは限らないよ!と言うエールのつもりで書きました。他の症例も早くアップしなくちゃいけないんですが・・・。

ステロイドが少し効いたのが症状をこじらせ、診断を難解にしたのかも知れません。折角なので上海でのセミナースライドも活用して記載してみます。

天疱瘡を疑う疾患群は色んなパターンがありますが、同じ病気でも病期や、それぞれの子の薬の相性だとか禁忌だとか、家庭の事情等の色んな考慮すべき事があります。その制限の中でどうやって診断や治療をするか?は皮膚科認定医としての経験と知識に基づく取捨選択が非常に大切になります。

難治性のアトピーはオーダーメイドの治療を「犬種や年齢」「今までの経過」「治療しての経過」から一緒に作って維持する事が大切です

10歳を超えての発症で、全方位的に鑑別を考える必要がありそうです。

「王道の膿皮症治療」とは「適切な種類の薬」「適切な量」「適切な期間」「適切な補助療法(外用)」です。